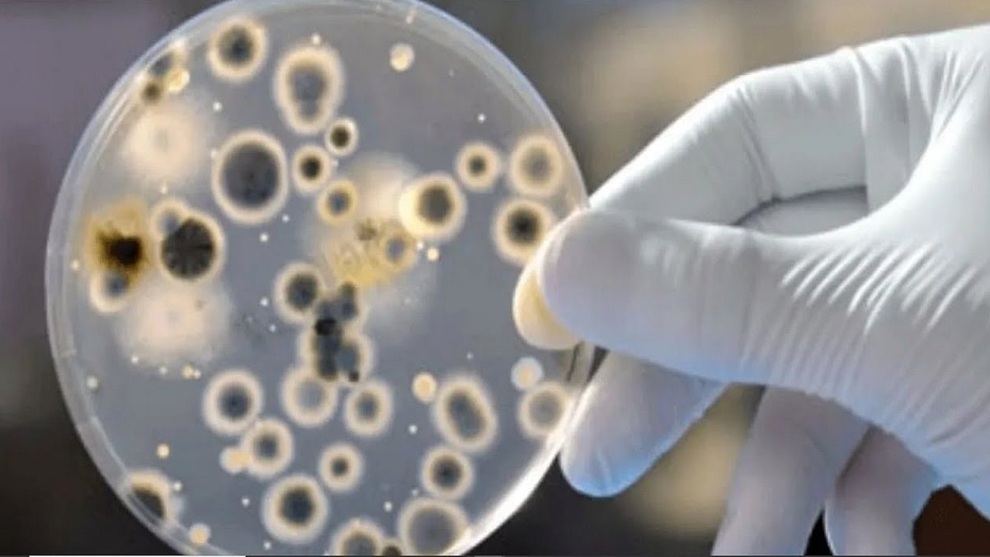

Mỹ phát hiện ca bệnh nấm nguy hiểm chết người có thể "kháng mọi loại thuốc"
(Dân trí) - Trung tâm Kiểm soát và Ngăn ngừa dịch bệnh Mỹ (CDC) thông báo về một số ca mắc bệnh nấm Candida auris nguy hiểm chết người và "kháng mọi phương pháp trị liệu hiện có".
Ảnh minh họa (Ảnh: getindianews).
The Hill đưa tin, các chuyên gia y tế công cộng đang bày tỏ lo ngại về một số ca bệnh nấm Candida auris tại Mỹ. Đây là bệnh đã từng xuất hiện ở Mỹ vào năm 2013, nhưng các ca bệnh mới gây lo ngại sâu sắc vì nó có khả năng kháng mọi loại thuốc điều trị hiện có.
Các ca bệnh mới này được ghi nhận ở viện dưỡng lão tại Washington DC và 2 bệnh viện tại Texas từ tháng 1 tới tháng 4 năm nay.
Theo CDC Mỹ, bệnh Candida auris là loại nấm men thường tấn công những người có hệ miễn dịch bị suy yếu. Cơ quan này cũng cho hay, các cụm bệnh nhân mới bị phát hiện mắc bệnh nấm đánh dấu lần đầu tiên Mỹ ghi nhận các trường hợp lây nhiễm nấm Candida auris từ người sang người.
Các cụm dịch mới phát hiện ở 2 thành phố dường như không liên quan tới nhau. Tỷ lệ tử vong trong 30 ngày ở toàn bộ các cụm dịch là 30%.
"Đây thực sự là lần đầu tiên chúng tôi chứng kiến nhiều bệnh nhân bị kháng thuốc như vậy và các bệnh nhân dường như lây chéo cho nhau", quan chức CDC Meghan Lyman nhận định.
Thế giới đã ghi nhận nhiều trường hợp mắc nấm Candida auris tại các bệnh viện và cơ sở chăm sóc sức khỏe dài hạn. Những người đã nhập viện trong thời gian dài, hoặc những người phải đặt ống thở, ống truyền thức ăn, hoặc ống thông tĩnh mạch là nhóm có nguy cơ nhiễm nấm cao nhất. Nó có thể gây nhiễm trùng vết thương, nhiễm trùng máu và dẫn tới tử vong.
CDC kêu gọi các nỗ lực giám sát và kiểm soát nhiễm trùng với nấm Candida auris để ngăn chặn sự lây lan thêm của mầm bệnh. CDC cũng thừa nhận họ chưa có đủ dữ liệu để đưa ra phương pháp chữa trị cho các ca bệnh kháng tất cả mọi loại thuốc.
Quan chức Lyman cũng cảnh báo, những trường hợp mắc Covid-19 nặng và phải sử dụng tới các biện pháp điều trị tích cực kể trên có nguy cơ mắc nấm Candida auris cao hơn.